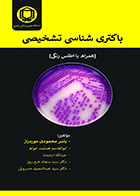
کتاب باکتری شناسی تشخيصی همراه با اطلس رنگی یاسر محمودی موردراز

-
کتاب نکات برتر بیماری های داخلی روماتولوژی مهدی ایزدی
179,100 تومان199,000تومان -
کتاب نکات برتر بیماری های داخلی کلیه مهدی ایزدی
179,100 تومان199,000تومان -
کتاب Key Book زنان و زایمان آزمون پیش کارورزی و پذیرش دستیاری
261,000 تومان290,000تومان -
کتاب نکات برتر بیماری های داخلی گوارش مهدی ایزدی
179,100 تومان199,000تومان -
کتاب نکات برتر بیماری های داخلی قلب مهدی ایزدی
179,100 تومان199,000تومان -
کتاب نکات برتر بیماری های داخلی غدد مهدی ایزدی
260,100 تومان289,000تومان -
کتاب تکنیکها و تشخیصهای آزمایشگاهی محمدرضا عابدی
640,000 تومان800,000تومان -
کتاب مجموعه سوالات کنکور کارشناسی ارشد و دکترا وزارت بهداشت مامایی 90-99
216,000 تومان240,000تومان -
کتاب CBCT در اندودانتیکس سالار چایچی سلماسی
1,062,000 تومان1,180,000تومان -
کتاب DDQ بی حسی موضعی مالامد 2013 امیدرضا فضلی صالحی
464,000 تومان580,000تومان -
کتاب راهنمای درمان های ارتودنسی در مطب سید مصطفی ابطحی
414,000 تومان460,000تومان -
-
-
کتاب مرور جامع DRS آمار زیستی ویراست دوم محمود یوسفی
792,000 تومان990,000تومان -
کتاب درس آزمون بیماری های چشم ویراست دوم بهروز امیدی آزاد
225,000 تومان250,000تومان -
کتاب بیومکانیک ایمپلنت های دندانی مهران همتی
1,242,000 تومان1,380,000تومان -
کتاب برای کنکور فیزیولوژی پزشکی داود نورآبادی
310,500 تومان345,000تومان -
کتاب درسنامه بیماری های مغز و اعصاب شکوفه علائی ویرایش دوم چاپ سوم
1,036,000 تومان1,295,000تومان -
کتاب رویان شناسی لانگمن 2019 توماس سادلر مسلم بهادری
392,000 تومان490,000تومان -
-
کتاب درس آزمون بیماری های چشم بهروز امیدی آزاد
200,000 تومان250,000تومان -
کتاب باکتری شناسی تشخيصی همراه با اطلس رنگی یاسر محمودی موردراز
960,000 تومان1,200,000تومان -
کتاب قدرت شگفت انگیز تغذیه ای سلول های بنیادی مهشید مرتضوی
355,500 تومان395,000تومان -
کتاب ژنتیک مولکولی انسانی استراخان جلد اول-مترجم نجات مهدیه و دیگران
450,000 تومان500,000تومان
-
کتاب نکات برتر بیماری های داخلی روماتولوژی مهدی ایزدی
تعداد صفحه 235 انتشارات پروانه دانش تالیف دکتر مهدی ایزدی - دکتر محمد کیانی
179,100 تومان199,000تومان -
کتاب نکات برتر بیماری های داخلی کلیه مهدی ایزدی
تعداد صفحه 221 انتشارات پروانه دانش تالیف دکتر مهدی ایزدی - دکتر محمد کیانی
179,100 تومان199,000تومان -
کتاب Key Book زنان و زایمان آزمون پیش کارورزی و پذیرش دستیاری
تعداد صفحه 189 انتشارات اندیشه رفیع تالیف دکتر علیرضا زادمهر - دکتر گلایول برهمن
261,000 تومان290,000تومان -
کتاب نکات برتر بیماری های داخلی گوارش مهدی ایزدی
تعداد صفحه 326 انتشارات پروانه دانش تالیف دکتر مهدی ایزدی - دکتر محمد کیانی
179,100 تومان199,000تومان -
کتاب نکات برتر بیماری های داخلی قلب مهدی ایزدی
تعداد صفحه 227 انتشارات پروانه دانش تالیف دکتر مهدی ایزدی - دکتر محمد کیانی
179,100 تومان199,000تومان -
کتاب نکات برتر بیماری های داخلی غدد مهدی ایزدی
تعداد صفحه 241 انتشارات پروانه دانش تالیف دکتر مهدی ایزدی - دکتر محمد کیانی
260,100 تومان289,000تومان -
کتاب تکنیکها و تشخیصهای آزمایشگاهی محمدرضا عابدی
تعداد صفحه 348 انتشارات حیدری تألیف دکتر محمدرضا عابدی
640,000 تومان800,000تومان -
کتاب مجموعه سوالات کنکور کارشناسی ارشد و دکترا وزارت بهداشت مامایی 90-99
تعداد صفحه 485 انتشارات کتابخانه فرهنگ تألیف گروه مولفین
216,000 تومان240,000تومان -
-
کتاب دست دوم تست درماتولوژی دکتر کرمی 98
تعداد صفحه 720 انتشارات طرلان تألیف دکتر مجتبی کرمی و دکتر مهشید بهرامی
50,000تومان -
کتاب درسنامه بیماریهای کودکان 6 دکتر کرمی 98
تعداد صفحه - انتشارات طرلان تألیف دکتر مجتبی کرمی - دکتر مهشید بهرامی
120,000تومان -
کتاب CBCT در اندودانتیکس سالار چایچی سلماسی
تعداد صفحه 300 انتشارات رویان پژوه تألیف سالار چایچی سلماسی
1,062,000 تومان1,180,000تومان -
کتاب DDQ بی حسی موضعی مالامد 2013 امیدرضا فضلی صالحی
تعداد صفحه 131 انتشارات شایان نمودار تألیف دکتر امیدرضا فضلی صالحی و همکاران
464,000 تومان580,000تومان -
کتاب راهنمای درمان های ارتودنسی در مطب سید مصطفی ابطحی
تعداد صفحه 302 انتشارات رویان پژوه تألیف دکتر سید مصطفی ابطحی - کتر سید محسن حسینی - دکتر آیدا اسماعیلی
414,000 تومان460,000تومان -
کتاب مجموعه سوالات کنکور ارشد و دکترا وزارت بهداشت ژنتیک 88-99
تعداد صفحه 520 انتشارات کتابخانه فرهنگ تألیف گروه مولفین
220,000تومان -
کتاب خلاصه کتاب زنان دنفورث جلد 2 Effortless Medicine-نویسنده پری خدام
تعداد صفحه 148 انتشارات آرتین طب تألیف پری خدام
16,800تومان -
کتاب ABS بافت شناسی داوود رمزی
تعداد صفحه 293 انتشارات آبادیس طب تألیف داوود رمزی
712,500 تومان950,000تومان -
کتاب ABS پاتولوژی داوود رمزی
تعداد صفحه 278 انتشارات آبادیس طب تألیف داوود رمزی
637,500 تومان850,000تومان -
کتاب مرور جامع DRS آمار زیستی ویراست دوم محمود یوسفی
تعداد صفحه 334 انتشارات جامعه نگر تألیف محمود یوسفی - علیرضا محبوب اهری
792,000 تومان990,000تومان -
کتاب درس آزمون بیماری های چشم ویراست دوم بهروز امیدی آزاد
تعداد صفحه 152 انتشارات تیمورزاده تألیف بهروز امیدی آزاد
225,000 تومان250,000تومان -
کتاب بیومکانیک ایمپلنت های دندانی مهران همتی
تعداد صفحه 344 انتشارات رویان پژوه ترجمه دکتر مهران همتی - دکتر یاسمن گنجی
1,242,000 تومان1,380,000تومان -
کتاب برای کنکور فیزیولوژی پزشکی داود نورآبادی
تعداد صفحه 420 انتشارات خسروی تألیف داود نورآبادی - علی محمد خانی زاده - دکتر یاسر عزیزی
310,500 تومان345,000تومان -
کتاب درسنامه بیماری های مغز و اعصاب شکوفه علائی ویرایش دوم چاپ سوم
تعداد صفحه 346 انتشارات تیمورزاده تألیف گروه نویسندگان ویراستار علمی دکتر شکوفه علائی
1,036,000 تومان1,295,000تومان -
کتاب رویان شناسی لانگمن 2019 توماس سادلر مسلم بهادری
تعداد صفحه 508 انتشارات ابن سینا تألیف توماس و سادلر ترجمه دکتر مسلم بهادری - دکتر عباس شکور
392,000 تومان490,000تومان -
کتاب دست دوم بافت شناسی جعفر سلیمانی راد -نوشته دارد
تعداد صفحه 352 انتشارات حیدری جعفر سلیمانی راد
899,000تومان -
کتاب بیوشیمی جامع پزشکی محمود دوستی
تعداد صفحه 528 انتشارات آییژ تألیف دکتر محمود دوستی و همکاران
243,000 تومان270,000تومان -
کتاب درس آزمون بیماری های چشم بهروز امیدی آزاد
تعداد صفحه 152 انتشارات تیمورزاده تألیف دکتر بهروز امیدی آزاد
200,000 تومان250,000تومان -
کتاب درسنامه پزشکی پیشگیری و اجتماعی جلد دوم کلیات خدمات بهداشتی بخش نخست جی ای پارک حسین شجاعی تهرانی
تعداد صفحه 278 انتشارات سماط تألیف جی. ای. پارک ترجمه دکتر حسین شجاعی تهرانی
486,000 تومان540,000تومان -
کتاب درسنامه پزشکی پیشگیری و اجتماعی جلد سوم کلیات خدمات بهداشتی بخش دوم جی ای پارک حسین شجاعی تهرانی
تعداد صفحه 534 انتشارات سماط تألیف جی. ای. پارک ترجمه دکتر حسین شجاعی تهرانی
810,000 تومان900,000تومان -
کتاب باکتری شناسی تشخيصی همراه با اطلس رنگی یاسر محمودی موردراز
تعداد صفحه 531 انتشارات حیدری تألیف یاسر محمودی موردراز و همکاران
960,000 تومان1,200,000تومان -
کتاب قدرت شگفت انگیز تغذیه ای سلول های بنیادی مهشید مرتضوی
تعداد صفحه 250 انتشارات تیمورزاده تألیف آلن سی سامرسال ترجمه دکتر مهشید مرتضوی
355,500 تومان395,000تومان -
کتاب ژنتیک مولکولی انسانی استراخان جلد اول-مترجم نجات مهدیه و دیگران
تعداد صفحه 482 انتشارات برای فردا ترجمه نجات مهدیه و دیگران
450,000 تومان500,000تومان